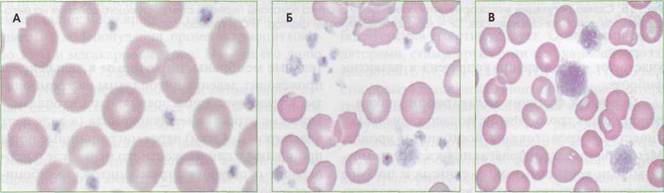

Полезное:
Как сделать разговор полезным и приятным
Как сделать объемную звезду своими руками
Как сделать то, что делать не хочется?
Как сделать погремушку
Как сделать так чтобы женщины сами знакомились с вами
Как сделать идею коммерческой
Как сделать хорошую растяжку ног?
Как сделать наш разум здоровым?
Как сделать, чтобы люди обманывали меньше
Вопрос 4. Как сделать так, чтобы вас уважали и ценили?
Как сделать лучше себе и другим людям
Как сделать свидание интересным?

Категории:
АрхитектураАстрономияБиологияГеографияГеологияИнформатикаИскусствоИсторияКулинарияКультураМаркетингМатематикаМедицинаМенеджментОхрана трудаПравоПроизводствоПсихологияРелигияСоциологияСпортТехникаФизикаФилософияХимияЭкологияЭкономикаЭлектроника

Тромбоциты
|
|
Тромбоцитопоэз
Дифференцировка и созревание клеток мега-кариоцитопоэза происходят в костном мозге, где из коммитированных, морфологически неиденти-фицируемых клеток-предшественников (КОЕ-Мгкц) формируются колонии мегакариоцитар-ных клеточных элементов. При созревании клетки проходят три морфологически дифференцируемые стадии: мегакариобласт, который не превышает 10% всей популяции, промегакариоцит (около 15%) и мегакариоцит (рис. 14) - на его долю приходится от 75 до 85%.
Процесс дифференцировки мегакариоцитар-ных элементов продолжается около 25 часов, такое же примерно время (около 25 часов) составляет созревание, а весь жизненный цикл - около 10 суток. Отличительной чертой клеточных элементов мега-кариоцитопоэза является их способность к эндоми-тозу (полиплоидизации) - делению ядра без разде-

Рис. 14. Мегакариоцит, диаметр 30-40 мкм. Ядро темно-фиолетового цвета, лопастное, с бухтообразными вдавле-ниями, фрагментированное. Хроматин распределен неравномерно, Цитоплазма обильная, содержит обильную зернистость
ления цитоплазмы, что приводит к появлению гигантского размера клеток (мегакариоцитов). В процессе мегакариоцитопоэза (рис. 15) клетки проделывают от 3 до 6 эндомитозов, что соответствует плоидности мегакариоцита от 8 п до 64 п.
Регуляция мегакариоцитопоэза осуществляется по принципу обратной связи: избыток тромбоцитов в крови тормозит тромбоцитопоэз, а тром-боцитопения его стимулирует. Основными регуляторами, стимулирующими мегакариоцитопоэз, являются ИЛ-1, ИЛ-3, ИЛ-4, ИЛ-6, ИЛ-11, фактор стволовых клеток, лейкоз-ингибирующий фактор, гранулоцитарно-макрофагальный колониестиму-лирующий фактор (ГМ-КСФ), гранулоцитарный колониестимулирующий фактор (Г-КСФ), эритро-поэтин, тромбопоэтин. К факторам, ингибирую-щим тромбоцитопоэз, относят тромбоцитарный фактор 4, трансформирующий фактор роста Рр ин-терфероны-а и -у и другие ингибиторы.
В а-гранулах мегакариоцитов содержится значительное количество белков: фактор Вилле-бранда, тромбоцитарный фактор 4, тромбоспон-дин, фибриноген, фибронектин, тромбоцитарный ростовой фактор, трансформирующие ростовые факторы, тромбоцитарный ингибитор коллагена-зы. Основная масса их синтезируется в мегакарио-цитах, некоторые белки, такие, как альбумин, фибриноген, IgG, поступают в клетку путем эн-доцитоза. Способность зрелых мегакариоцитов к эндоцитозу проявляется в явлении эмпириопо-лезиса, суть которого заключается в захвате ге-мопоэтических клеток. Частота его возрастает при злокачественных новообразованиях. Тромбо-цитарная пероксидаза присутствует на всех стадиях созревания клеток мегакариоцитарной линии, включая тромбоциты. Мегакариоциты, синтезируя трансформирующий ростовой фактор (3,
Тромбоциты

|
Рис. 15. Схема регуляции мегакариоцитопоэза. Внизу рисунка показаны периоды стимулирующего действия на мега-кариоцитоз основных стимуляторов. LIF - лейкоз-ингибирующий фактор, ТРО - тромбопоэтин
участвуют в накоплении коллагена и развитии фиброза.
Основная функция мегакариоцитопоэза -репопуляция тромбоцитов, поддержание их количества в кровотоке на постоянном уровне. Мегакариоциты располагаются в костном мозге вблизи костно-мозговых синусов и по мере созревания внутрь клетки врастают раздели-
тельные мембраны, по которым в дальнейшем происходит деление цитоплазмы на тромбоциты. Существует точка зрения, что цитоплазма-тические отростки мегакариоцита (в виде лент диаметром 2-4 мкм) через миграционные поры проникают в синусы костного мозга, где и происходит отшнуровка тромбоцитов (тромбоци-тообразование).
Жизненный цикл тромбоцитов
Около 1/3 всей массы тромбоцитов находится в селезенке (селезеночный пул): при спленомегалии этот пул возрастает, что может приводить к перераспределительной тромбоцитопении. При стимуляции адренорецепторов (физическая нагрузка, стресс) происходит выброс тромбоцитов в циркуляцию, что приводит к кратковременному тромбо-цитозу (рис. 16). После спленэктомии также в течение некоторого времени наблюдается тромбоцитоз, который иногда достигает очень больших величин (до 800-1200 х 107л). Остальные 2/3 тромбоцитов циркулируют в крови. Средняя продолжительность жизни тромбоцитов составляет 9-10 суток.
Референтные значения. У здорового человека количество тромбоцитов может несколько менять-
ся в течение суток. Нормальное содержание тромбоцитов в крови колеблется в пределах 150-320 х 109/л. (В последнее время в связи с поступлением на отечественный рынок зарубежных гематологических счетчиков и анализаторов, в инструкции к которым даются зарубежные нормы, стали приводить значения нормального содержания тромбоцитов в диапазоне от 150 до 450 х 109/л.)
При отсутствии в крови гемопоэтических стимулов общий объем циркулирующих тромбоцитов довольно постоянен. В патологических условиях количество и объем тромбоцитов могут меняться (рис. 17). При снижении продукции тромбоцитов гемостатический потенциал может быть частично компенсирован за счет
Тромбоциты

|
Рис. 16. Жизненный цикл тромбоцитов. Тромбоциты образуются в костном мозге из мегакариоцитов, примерно 2/3 периферического пула находится постоянно в системе циркуляции, 1/3 - в селезенке. При стимуляции адрено-рецепторов может возникнуть временный тромбоцитоз из-за выброса тромбоцитов в систему циркуляции из костного мозга и селезенки, Опустошение тромбоцитов в селезенке происходит и при ДВС-синдроме при тромбоцитопе-нии потребления, в последнем случае могут появляться макротромбоциты с недостаточными функциональными свойствами адгезии и агрегации - возникает тромбоцитопатия
|
Рис. 17. Тромбоциты в периферической крови: А - нормальные тромбоциты, Б - анизоцитоз тромбоцитов при хроническом моноцитарном лейкозе (нарушение дифференцировки на уровне полипотентных коммитированных предшественников мегакариоцитопоэза), В - гигантские тромбоциты (макротромбоциты) при аутоиммунной тромбоцитопении
повышения их объема. В обратной ситуации, при повышении количества тромбоцитов выше 450 х 109/л, объем тромбоцитов не снижается ниже определенного физиологического уровня. Соответственно общий объем тромбоцитарного пула в крови возрастает пропорционально увеличению количества тромбоцитов. Это может
приводить к увеличению тромбогенного потенциала.
С помощью автоматических гематологических анализаторов можно измерить средний объем тромбоцитов (MPV), дисперсию распределения тромбоцитов по объему (RDW) и оценить гистограмму распределения тромбоцитов по объему.
Структура тромбоцитов
Тромбоцит - безъядерная сферическая клетка диаметром 2-4 мкм, средний объем 7,5 мкм3 (от 3 до 10 мкм3, или фл-фемтолитры). Микроформы тромбоцитов имеют диаметр менее 1,5 мкм,
макроформы могут достигать 6-10 мкм. Интакт-ные тромбоциты имеют форму диска или пластины диаметром 2,8-3,4 мкм, толщиной 0,8-1,2 мкм и объемом от 5,7 до 8,9 мкм3 (рис. 18). В циркули-
Date: 2015-05-19; view: 868; Нарушение авторских прав